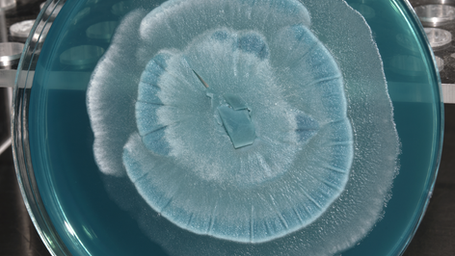
Fungi-to-fuel: Oleaginous Fungi Research Could Reshape Biodiesel Production

what we do.
MycoStories is a global innovation & advisory platform working with start-ups, investors, corporates and research institutions.
By fostering cross-sector collaboration and leveraging a global network, we help founders scale their businesses, guide investors and industry leaders in identifying high-potential opportunities, and empower researchers to translate their work into real-world applications.
MycoStories is dedicated to accelerating growth, driving innovation, and amplifying the impact of fungi-based solutions and conservation initiatives.
work with us.
Covering fungal innovation in the food industry, agriculture, health or materials, our team of subject-matter experts will support you to make the right scientific, operational and commercial decisions, saving you both time and money.
Subscribe to our newsletter for the latest research and industry updates, collaboration opportunities, and new developments within the network.